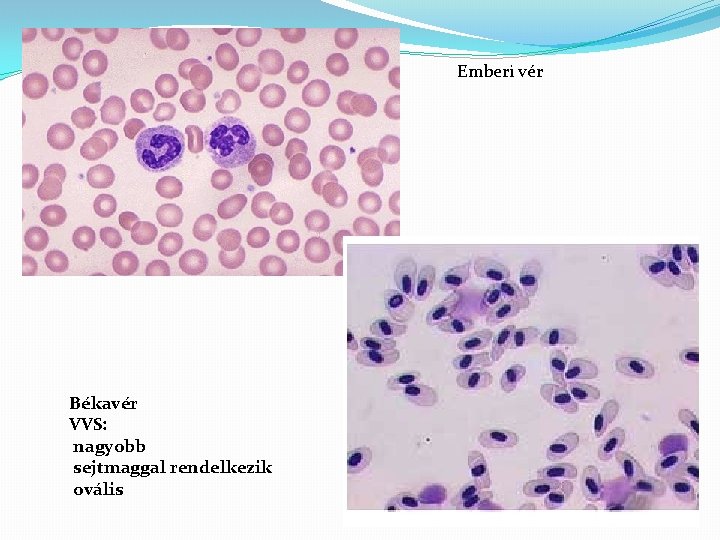

A vr sszettele alkoti Ismtls Vr zrt keringsi

- Slides: 25
A vér összetétele, alkotói
Ismétlés �Vér: zárt keringési rendszerben keringő testfolyadék (belső környezet!) �Tápanyagokat, légzési gázokat, bomlástermékeket. . . szállít �Szövettanilag: folyékony sejtközötti állományú kötőszövet �Szabályozás �Védekezés �Önvédelem - véralvadás
Összetétele-mennyiségi viszonyok �A teljes vértérfogat: 5 -5, 6 dm 3 Keringő vér Tartalék vér – lép, máj, tüdő, csontvelő bélfal, bőr alatt � 55% vérplazma � 45% alakos vagy sejtes elemek
A vérplazma összetétele �Szervetlen alkotók: 90% víz 1 -2% ionok (kationok: Na+, K+, Ca 2+, Mg 2+ anionok: Cl-, HCO 3 -, HPO 42 -, SO 42 -) �Szerves alkotórészek: 1 -2% kis molekulájú szerves anyagok pl. glükóz (5, 5 mmol/dm 3), aminosavak, szteroidok karbamid, húgysav 7 -9% fehérjék (albuminok, globulinok, fibrinogén
Kiegészítés �Albuminok: egyszerű fehérjék ozmotikus nyomás kialakítása, p. H puffer aminosav-, lipid-, ionszállítás A máj termeli. �Globulinok: Összetett fehérjék (glükoproteinek) immunfehérjék, vércsoportfehérjék (antitest), véralvadási faktorok (I. -XIII. ) hormonszállítás A máj és a fehérvérsejtek termelik. �Fibrinogén: Egyszerű fehérjék Véralvadás A máj termeli
Kiegészítés �Homeosztázis 1. Vér p. H: 7, 4 A megengedett változás kevesebb mint 0, 05 Pufferek biztosítják (olyan oldatok, amely egy határon belül képesek az állandó kémhatást biztosítani. Általában -Gyenge sav erős bázissal alkotott sója+gyenge sav -vagy gyenge bázis erős savval alkotott sója+gyenge bázis a, fehérje puffer b, szénsav-bikarbonát rendszer � 2. Általában magas Na, Cl koncentráció � 3. Hormonhatásra glükóz, as. , lipidek dinamikus egyensúlya
A vér alakos (sejtes) elemei �Vörösvértestek: a legnagyobb mennyiségben előforduló 4, 5 -5, 5 millió/mm 3 jellegzetes „fánk” alak képződés: a vöröscsontvelőben élettartam: 120 nap lebomlás: lépben és a májban
Kiegészítés �A vörösvértest képzés helye (is!) a vörös csontvelő Az érés során - sejtmag lebomlik (horpadás) - sejtalkotók lebomlanak pl. mitokondrium, Golgi - csak glikolízis lehetséges - hemoglobin tartalom nő �A képződését fokozza: - alacsony O 2 szint - vese eritropoetin hormonja �A képzéshez kell: B 12, B 6, C vitamin, folsav �(a vér 1%-a naponta kicserélődik)
Emberi vér Békavér VVS: nagyobb sejtmaggal rendelkezik ovális
A vörösvértestek feladata � � Légzési gázok szállítása O 2 kötődik a hemoglobinhoz (kissé a CO 2 is) A CO 2 szállítása oldva a vérplazmában történik
Vörösvértestek mennyisége �Növekedhet: �tengerszint feletti magasság � vérdopping (tiltott!) � EPO (vese hormonja, a vérképző őssejtekre hat (tiltott!) �Csökkenhet: vérszegénység � - vérzés � - sarlósejtes vérszegénység = mutáció � - vashiányos vérszegénység � - vészes vérszegénység = B 12 vitaminhiány � - hemolízis (pl. kígyómérgektől)
Sarlósejtes vérszegénység Hipotóniás oldatban Hipertóniás oldatban
Fehérvérsejtek �amőboid alak d = 5 -20 μm � 5 -8 ezer db/mm 3 � sejtmag van � önálló mozgás van (amőboid) � keletkezés: vöröscsontvelői őssejtek � érés: speciális funkció elnyerése � élettartam: akár 10 év � pusztulás: fertőzések helyén, nyirokszervekben � funkció: belső védekezés, immunitás
limfociták (nyiroksejtek ) falósejtek monociták (nagy T-limfocita B-limfocita falósejtek) granulociták (kis falósejtek) bazofil eozinofil neutrofil
Fehérvérsejtek mennyisége Mitől csökkenhet a mennyiség? -vírusfertőzés (pl. HIV) - autoimmun betegség - sugárkezelés Mitől nőhet a mennyiség? leukémiás vér - baktériumos fertőzés - gyulladások - leukémia (fehérvérsejtszám: > 100 000 db/mm 3)
A HIV vírus elterjedtsége 2004 -ben
Vérlemezkék - lemez alak - d = 1 -3 μm - 150 -300 ezer db/mm 3 - smag nincs - önálló mozgás nincs - keletkezés: vöröscsontvelői � őssejtek - érés: - sejthártyával borított � plazmatöredékek - élettartam: - pusztulás: vérrögképződéskor - funkció: véralvadás
reflexes érösszehúzódás vérlemezkék dugót képeznek Véralvadás
reflexes érösszehúzódás F III. (aktív) vérlemezkék + sérült sejtek protrombin (inaktív) (aktív) F XIII. K (aktív) vitamin F XII. (inaktív) (aktív) F XI. (inaktív) (aktív) Ca+ fibrinogén fibrin (inaktív) (aktív) vízben oldhatatlan, fibrilláris fehérje hálót képez összesen XIII faktor
Fibrinháló + fennakadt sejtes elemek = vérlepény Kiszűrődik: vérsavó Vérsavó = fibrinmentes vérplazma
vérzékenység (hemofília) trombózis - mutáció: X kromoszóma - bármely faktor hiánya - Mo: kb. 3000 beteg - erek elzárása - tüdő-, agyembólia